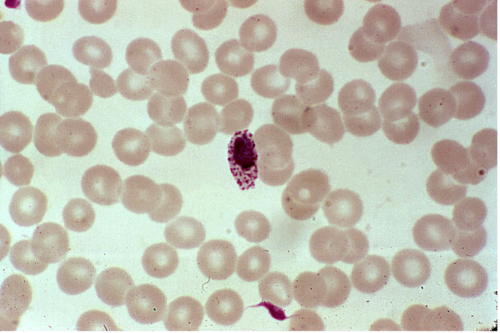

The malaria parasite co-evolved with human life and is estimated to have caused half of all human deaths in history – including those of Genghis Khan, Alexander the Great, and King Tut. Considered against this span of history, it was a relatively short time ago that Sir Ronald Ross made the discovery that malaria is spread by female anopheles mosquitoes. He designated August 20th as ‘World Mosquito Day’ in honor of this landmark scientific insight.
Since that day in 1897, in an effort to eliminate the deadly disease, scientists around the world have developed and deployed an array of innovative tools that have rendered malaria infection both preventable and treatable. Nevertheless, malaria continues to kill more than 600,000 people and sickens more than 240 million people annually. The goal of malaria eradication remains elusive.

However, this is not for lack of trying. In the 1950s and 60s, the World Health Organization (WHO) launched a global Malaria Eradication Program with high hopes, largely based on the ‘miraculous powder’ DDT for vector control. Although the campaign succeeded in eliminating malaria in many regions of the world, the effort fell short in the highest-burden areas. A hard lesson was learned. There is no ‘silver bullet’ – no single intervention that can eliminate malaria.
Malaria programs regrouped over the next decades with an emphasis on ‘control’ of the disease. The females of the anopheles falciparum mosquitos do most of their blood feeding at night, hence the distribution of insecticide-treated bednets proved to be an excellent tool to block transmission, particularly in children and pregnant women. Bednet use for prevention paired with effective diagnosis and treatment became an incredibly effective means to improving mother and child health outcomes. During the era of the Millennium Development Goals (MDGs), malaria mortality dropped by 60% and all-child mortality dropped by 25%. Malaria was celebrated as the poster child of the MDGs, showing what can be achieved with concerted global effort and a multi-pronged approach.
But – after all this dramatic progress, malaria programs hit a plateau in both funding and results around 2015. The ever-mutating landscape of drug and insecticide resistance is diminishing the efficacy of previously powerful treatment and prevention tools, putting more people at risk of disease. In parallel, a warming climate increases the range of malarial mosquitoes. The interactions between human health behavior, agriculture, water management, and urbanization are complex and varied. They are deeply integrated with local human cultures and strikingly different from one place to the next. It is now clear that heterogenous strategies and an ‘all of society’ response are required.
New malaria surveillance data platforms are moving away from the ‘one size fits all’ campaigns of the MDG era and driving more tailored responses to direct the right tools to each environment. New advances in diagnostics, medicines, new types of vector control, and perhaps most exciting, long-sought effective malaria vaccines are finally becoming available.
The COVID-19 pandemic response benefited immensely from malaria surveillance platforms. Front-line workers in malaria programs, already known and trusted by their communities, served as vital antennae detecting the emergence of fever and informing national health systems’ response to the COVID-19 crisis. Now, with the malaria burden rising, deaths from malaria are outpacing death from COVID-19 in most malaria-endemic countries, and the socio-economic losses from a rising malaria burden are taking a toll. While continuing to respond to the demands of COVID-19, ministries of health now find themselves struggling to respond to increasing malaria morbidity and mortality with diminished resources, both financial and human.
As nations increasingly recognize the importance of self-reliance for health systems and supply chains, the COVID-19 pandemic has been catalytic for a new geo-political dynamic in global health. The rising cadre of health leaders in malaria-endemic countries have the lived experience and the determination to usher in a new era of local leadership in global health as we approach the malaria end game. This transition comes just in time. After decades of remarkable progress and reductions in the malaria burden, since around 2015, gains against malaria are perilously close to reversal.
Eradicating malaria will test the limits of human capacity, but we can and should outwit the malaria parasite and end needless malaria deaths.
On 20 August 1897, in Secunderabad, Ross made his landmark discovery. While dissecting the stomach tissue of an anopheline mosquito fed four days previously on a malarious patient, he found the malaria parasite and went on to prove the role of Anopheles mosquitoes in the transmission of malaria parasites in humans.
Lisa Goldman-Van Nostrand is an Advocacy and Communications Advisor at GLIDE. She has focused on malaria for 17 years, serving as Chief of Staff at Sumitomo Chemical, a leader in the development and innovation of new vector control tools for public health. Lisa is an Advisor to the Board Leadership of the RBM Partnership to End Malaria and has fulfilled a range of advocacy, policy, and communications roles for the Partnership since 2012. Prior to 2012, Lisa managed the inauguration of Sumitomo Chemical’s joint venture with A to Z Textile Mills in Tanzania and produced the Olyset photo library and “Palufoot” PSA campaigns. In 2005, she began her work in malaria through her role as an international producer of Youssou N’Dour’s Africa Live: Roll Back Malaria concert. A documentary of the event was televised globally on the BBC, PBS, Arte, TV5, and across Africa, and was viewed by more than a billion people. In 2004, Lisa was Internet Tsarina for Quincy Jones’ We Are the Future concert in Rome.